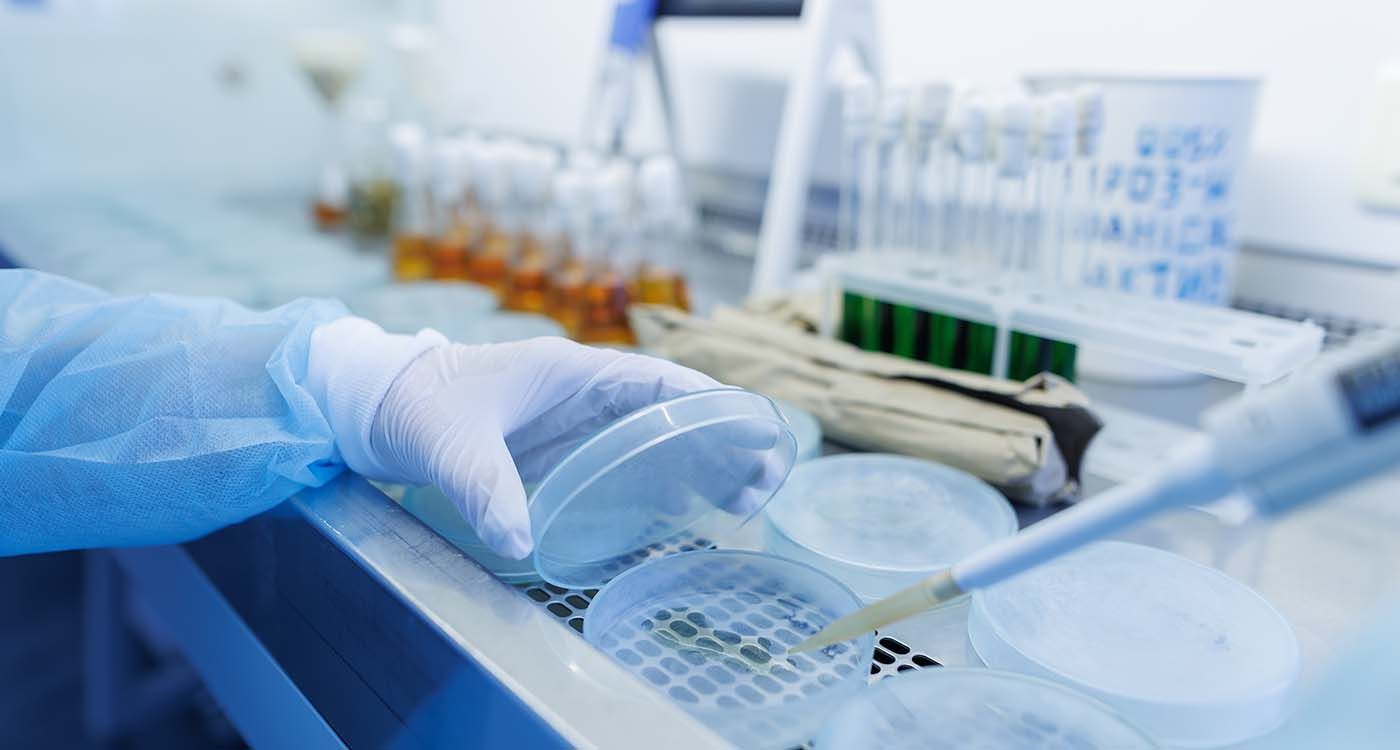
«Bactérie miroir»: et si la prochaine pandémie venait du labo?

Des scientifiques lancent un appel à la vigilance face à la possibilité de créer, en laboratoire, une «bactérie miroir» fondée sur une chimie opposée à celle de toute vie terrestre. Une avancée encore théorique, mais porteuse de graves enjeux bioéthiques.
Et si une forme de vie totalement étrangère, construite selon des règles inversées aux nôtres, voyait le jour dans un laboratoire? Cette hypothèse, longtemps cantonnée à la science-fiction, prend une tournure plus concrète avec les avancées en biologie synthétique. À l’origine de cette inquiétude: la possible création d’une bactérie miroir, utilisant une chiralité inversée, c’est-à-dire des molécules symétriques, mais en version opposée à celles utilisées par tous les êtres vivants connus.
Dans notre monde, les acides aminés (qui forment les protéines) ont une forme «gauchère» (notée L), et les sucres une forme «droitière» (notée D). Une vie miroir, en revanche, fonctionnerait avec des acides aminés droitiers (D) et des sucres gauchers (L), une inversion complète et radicale. Résultat: notre système immunitaire ne reconnaîtrait pas ces entités, nos enzymes ne pourraient pas les dégrader, et aucune bactérie naturelle ne serait capable de les concurrencer ou de les éliminer.
Un appel mondial à la vigilance
En décembre 2024, 38 chercheurs internationaux, dont plusieurs prix Nobel, ont publié une tribune dans Science pour réclamer un moratoire international. Leur message est clair: il faut stopper, ou du moins encadrer strictement, les recherches visant à créer de telles formes de vie artificielles, qui pourraient constituer une menace pour l’équilibre biologique mondial.
Car même si aucun organisme miroir n’a encore été créé, plusieurs étapes ont déjà été franchies. Des peptides inversés, de l’ADN et de l’ARN miroir, et même des ribosomes expérimentaux ont vu le jour. Les scientifiques estiment que l’assemblage d’un être vivant complet utilisant cette chimie inversée pourrait être possible dans les 10 à 30 prochaines années.
D’un point de vue scientifique, cette création serait une avancée majeure; elle ouvrirait la porte à une vie alternative, indépendante de notre biologie. Des protéines inversées, par exemple, pourraient transporter des médicaments sans être attaquées par nos défenses, offrant de nouvelles pistes thérapeutiques.
Mais les risques sont bien réels. Une bactérie miroir, conçue pour être résistante, pourrait échapper à tout contrôle. Aucun antibiotique actuel ne pourrait l’arrêter. Si elle s’installait dans l’environnement, elle pourrait coloniser certaines niches sans concurrence naturelle. Plus grave encore, certaines enzymes miroir pourraient, par effets mal connus, perturber nos propres mécanismes biologiques.
Vers une régulation internationale?
Dame Angela McLean, conseillère scientifique du gouvernement britannique, a récemment qualifié ce sujet de «priorité bioéthique mondiale». En mars 2025, une conférence organisée par l’Institut Pasteur et l’Université de Cambridge a tenté de poser les premières pierres d’un cadre juridique international. Mais pour l’instant, aucune loi n’interdit explicitement ces recherches.
Certains chercheurs appellent néanmoins à ne pas freiner l’innovation: selon eux, une vie miroir aurait besoin d’un environnement chimique très spécifique pour survivre, et ne pourrait pas directement interagir avec notre ADN ou nos cellules. Pourtant, dans un monde où les laboratoires sont interconnectés et où les accidents existent, la prudence reste de mise.
La bactérie miroir n’existe pas encore, mais son spectre suffit à faire vaciller nos certitudes. En inversant les bases mêmes de la biologie, cette forme de vie soulève une question: jusqu’où voulons-nous aller dans notre capacité à créer et à maîtriser le vivant?
La chiralité, c’est quoi?
La chiralité est une propriété des molécules: comme nos mains, certaines molécules existent en deux versions symétriques qu’on ne peut superposer. Dans la nature, la vie a «choisi» une version pour ses composants: les acides aminés gauchers (L) et les sucres droitiers (D). Une vie miroir utiliserait l’inverse. Elle serait invisible à notre système immunitaire et résistante à nos traitements, car notre biologie ne sait pas interagir avec ces formes inversées.

Commentaires